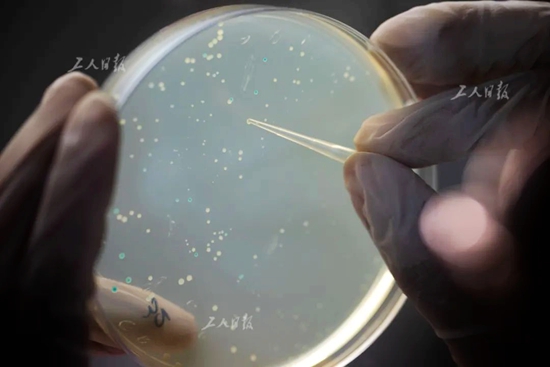

[工人日报] 麦田里的“粮”心守护者
小麦是世界上分布最广、种植面积最大的作物,也是中国人最重要的“口粮”之一。
从1981年中国农业科学院建立我国第一个小麦加工品质实验室开始,就有这样一群人,他们每天游走于田间地头,与小麦相伴,为的就是能够选育出优质高产的小麦品种,保证我国的粮食安全。在他们的努力下,我国小麦单产水平不断提高,优质品种不断问世。

6月7日,位于北京北三环内的农科院试验田内,来自作科所的研究员赵林姝(右一)正和工作人员在收小麦试验材料。

6月7日,位于北京北三环内的农科院试验田内,科研人员为创制小麦新种质,开展大规模杂交,数以千计的白色杂交袋在风中摇曳。
6月21日,夏至,北半球一年中白昼最长的一天。
37℃的“桑拿天”犹如蒸笼一般,闷热难耐。位于北京北三环内的中国农业科学院(简称:农科院)试验田内,小麦一片金黄,偶尔一阵风起,麦浪滚滚,蔚为壮观。这里是北京市三环内唯一的麦田,因其特殊的地理位置和科研价值,被人们称为“最珍贵麦田”。
麦熟一晌,虎口夺粮。对于从事小麦研究的农科人而言,这是收获的季节,也是与天气赛跑的时节,各个试验田内一片繁忙。

6月16日,农科院作科所顺义基地的麦田里,毛新国(图右)正带领学生选种。他形象地将此比作“小麦选美大会”,株高、分蘖、穗形、穗层、株型等都是要考察的直观指标。

6月15日,农科院作科所顺义基地的麦田里,一名工作人员正提着水杯走向麦田。夏日里,这样的大号水杯在这里几乎是每个人的标配。

6月15日,农科院作科所顺义基地的麦田里,附近的村民带着小孩在麦田里拍照留影。每年小麦成熟的时候,成片的麦田总能吸引不少人到此“打卡”。
在距“最珍贵麦田”约50公里外的农科院作科所顺义基地内,来自国家小麦产业体系种质资源鉴定与新种质创制岗位的科学家毛新国忧心忡忡,天气预报说第二天有雨。为了“夺粮”,他们加紧了收割的步伐。

6月21日晚,农科院作科所顺义基地的麦田里,工作人员正在抢收小麦。

6月21日,农科院作科所顺义基地的麦田里,毛新国(图右)正带着学生在收割小麦。
俯身弯腰,左手搂麦,右手握镰,顺势一拉,一大把麦子就被收割归拢,这叫走镰。毛新国喜欢这样的收麦方式。“沉甸甸的麦穗就是生命的分量,每次收割不光是一次体力上的付出,也是和小麦的一次对话,这些是机器收割无法体会的。”毛新国说,选种、种植、管护……等弯腰收割时,不光能感受丰收的喜悦,还能提升自己的修养。他认为,这种从实践中得出结论的过程就是一种感悟,“妙不可言”。

6月21日傍晚,农科院作科所顺义基地的麦田里,工作人员正将收割下来的小麦送进收割机脱粒。

6月21日,毛新国与学生将刚脱粒的小麦装上拖拉机。

6月15日,农科院作科所顺义基地,结束了一天的工作后,毛新国(右一)和工作人员一起乘坐三轮车返回住所。
与普通农田里整齐划一的小麦不同,这里种了数千份小麦种质材料,它们高低错落、青黄相间、形态各异,因此这里曾被戏称为“狗啃的麦田”。
就是在这片麦田里,经过41年的干旱和人工模拟高温环境实验,科学家已筛选出110多份抗旱耐热性突出的小麦种质资源,许多改良后的小麦品种被推广到了全国各产区落地生根,最终变成了人们餐桌上的美味。

6月15日,农科院作科所顺义基地的食堂内,科研人员正在吃晚饭。与城里相比,这里的条件相对艰苦,饭菜也比较简单。

6月15日,毛新国提着马扎在育种田里查看小麦的生长情况。

6月16日晚,硕士生导师毛新国在结束了一天的田间工作后在顺义基地宿舍和学生讨论课题进展情况。
在顺义基地,像毛新国这样的科学家随处可见。单从外表看,他们和普通农民完全没有区别,只有当他们穿上白色大褂,在田间指指点点,在本上勾勾画画才会“暴露”他们的身份。

6月17日,农科院作科所的实验室内,研究生范子培正将涂有转化菌液的培养基放入37℃培养箱培养,随后挑取单克隆进行基因测序。

6月17日,农科院的一处试验田内,李龙博士(左一)正带着学生测量农艺性状。

6月17日,农科院作科所的实验室内,一名工作人员正小心翼翼地将烘干的麦穗从袋子中取出。为了保证数据的准确,麦穗粒数和麦芒都要完好无损。

来自河南农业大学的客座博士研究生张艳菲正在调查小麦穗粒数。穗粒数和亩穗数、千粒重是决定小麦产量的三要素。
“真的被震惊到了,没想到我们课堂上学的那些品种就是在这里被孕育出来的。”说起初来农科院的感受时,即将攻读博士学位的王晋萍这样描述,“在这里当农民可不轻松,不光要起早贪黑,还要给小麦做标记、量株高、数穗粒,环环相扣,一步也不能错。”
炎炎烈日下,王晋萍将自己包裹得严严实实,即使这样,胳膊和脖子有时还是会被晒伤,又痒又疼。忙完地里的活儿,到了下午她就要赶回实验室对新选的小麦材料进行基因检测。王晋萍说:“虽说我们从事的是品种创新、基因改良的工作,但农田的活儿是一点也不能落下。”

6月17日,农科院作科所的实验室内,王晋萍正在统计不同小麦品种的发芽率。
科研人员正在挑取阳性菌落,用于后续的基因测序。

一名科研人员正在进行分子生物学实验。

6月17日,农科院作科所的实验室内,李龙博士(左一)正和学生分析小麦根系构型。

6月17日,农科院作科所的实验室内,工作之余的科研人员正在交流心得。

6月15日,两只蝴蝶在麦田中飞舞。
到了夏忙时节,中国农业科学院作科所的科研人员经常要在实验室和育种田里两头奔波,经常一星期也回不了一趟家,但对于这样的忙碌,他们却习以为常。有时为了能够培育出耐高温的小麦品种,他们常常要在四五十度的大棚内工作。来自作科所的李龙博士说:“一年辛劳不就为了收获嘛?何况我们收获的不光有粮食,还有珍贵的科研数据和国家对我们的信任。”
6月22日,大雨如期而至。经过前一天晚上加班收割,500多份小麦种质材料全部归仓。看着这些材料,毛新国像是看着自己的孩子,眼里满是希望。


